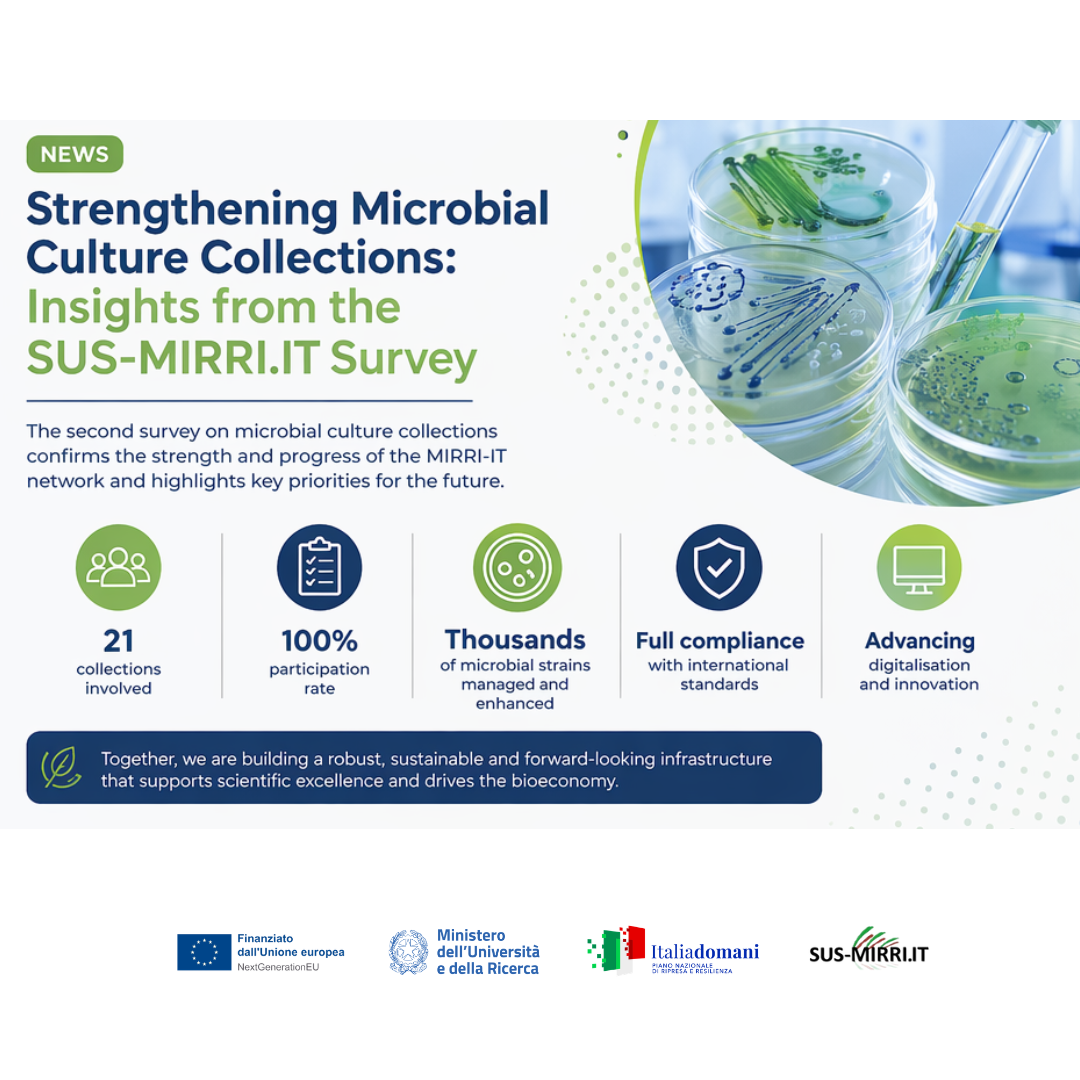

The SUS-MIRRI.IT project continues to advance the Italian research infrastructure for sustainable bioscience and bioeconomy through a comprehensive assessment of microbial culture collections.
As part of Work Package 2, a second survey on microbial culture collections has been successfully conducted, providing a detailed and up-to-date overview of the current status, achievements, and challenges across the MIRRI-IT network.
The survey reached full participation, with all involved collections contributing valuable data on key aspects such as governance, quality management systems, biosafety and biosecurity, legal compliance, preservation strategies, digitalisation, and service provision.
Among the most significant outcomes:
- A strong adoption of the Quality Management System, implemented by the vast majority of collections
- Full compliance with international regulatory frameworks, including the Nagoya Protocol
- A high level of engagement in biosafety practices and continuous training
- Increasing digitalisation, with all collections contributing to the National Catalogue
- Significant growth in microbial resources, with thousands of strains newly acquired and authenticated
At the same time, the survey highlights important areas for further development, including the need to strengthen governance frameworks, improve disaster recovery strategies, and ensure long-term sustainability.
Overall, the results confirm the strategic importance of MIRRI-IT as a coordinated and forward-looking infrastructure, capable of enhancing scientific excellence, supporting innovation, and fostering collaboration at both national and European levels.
This survey represents not only a monitoring tool, but also a key driver for continuous improvement and future development of microbial culture collections. Read more: